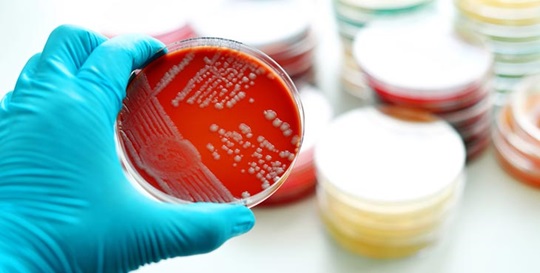

Influenza
Die Influenza, auch echte Grippe genannt, ist eine saisonale Infektionskrankheit, die durch Influenza-Viren ausgelöst wird. Erfahren Sie mehr über Symptome, Ansteckung, Risikogruppen, Therapien und die Bedeutung der Impfung.
Mehr erfahren